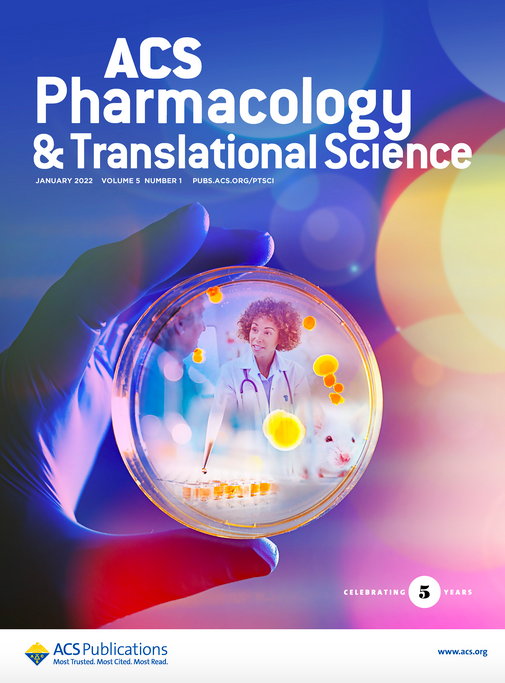
Translation is the art of creating value for patients. That's why I am thrilled to join ACS Pharmacology &amp; Translational Science as Topic Editor! My goal is to make manuscripts on materials and their translation even stronger and more impactful <a href="/ACSBioMed/">ACS Publications Bio & Med Chem Content</a> <a href="/ACSPublications/">ACS Publications</a>

Matoori Lab
@matoori_lab
Bioengineering Lab at Faculté de Pharmacie, Université de Montréal - Translating Science into Lives - Drug formulation, biomaterials, clinical research
ID: 1433524360653025280
02-09-2021 20:17:03
50 Tweet
109 Takipçi
100 Takip Edilen

Translation is the art of creating value for patients. That's why I am thrilled to join ACS Pharmacology & Translational Science as Topic Editor! My goal is to make manuscripts on materials and their translation even stronger and more impactful ACS Publications Bio & Med Chem Content ACS Publications

nature identified targeted genetic therapies among their seven technologies to watch in 2022. Several researchers PharmTech_UdeM are developing new technologies in this space Davide Brambilla Matoori Lab

Excellent talk by Prof. Olivia Merkel @LabMerkel Universität München today at Topics in Bioengineering Harvard SEAS and lots of fun and great insights at the virtual happy hour with Prof. Merkel, @Irene_dLz, Michael Dunne and engin kızılırmak (💙,🧡)🔴✨. Thank you @Irene_dLz for organizing this event





Very glad to see our new paper with Dave Mooney out in Biomaterials! We tested our liposomal lactate assay in fresh capillary blood in an IRB-approved study. So grateful to be translating this technology with Wyss Institute Rushdy Ahmad, PhD David Levine sciencedirect.com/science/articl…



Fantastic meeting w/ my PhD advisor Jean-Christophe Leroux ETH Zurich. He sketched out the three essential graphs of tumor-targeting nanoparticles followed by a passionate conversation about major conceptual breakthroughs in drug delivery in the last and next fifty years.


Thrilled to announce that I was awarded the NSERC / CRSNG Discovery grant. Such a five-year grant is a major game changer for a young PI. Sitting by Lake Zurich and thinking about all the research we'll do with that grant


Is it time for #radiology to get serious about #transhealth? More info about the gender of patients enables radiologists to improve their care and become patient-oriented physicians, finds new global study in EJR. buff.ly/3868GkZ @ELS_Radiology Simon Matoori


New paper out on transgender medicine from Matoori Lab (clinical track) and clinicians Dow-Mu Koh: how well can we document gender / assigned sex at birth in radiology? Important implications for cancer screening (breast: transmen, prostate: transwomen) ejradiology.com/article/S0720-…

Very excited that I was awarded the Fonds Servier grant from Faculté de pharmacie along with my collaborator Prof. Sylvie Marleau! We received the grant for a project on next-generation formulation strategies of peptides for the treatment of myocardial infarction 💔➡️❤️


Thank you Controlled Release Society #CRS2022 for giving me the opportunity to talk about vesicular diagnostics today! Had so much fun and am very grateful for the fantastic questions!


Congratulations to Davide Brambilla and Jin Wang, awardees of the TMD session! 👏🏻🤩 Thanks to Steinbach-Rankins Lab and Simon Matoori for moderating the session 🗣 #CRS2022 Controlled Release Society Young Scientist Committee YSC-CRS


Many congratulations to Davide Brambilla and Jin Wang for your fantastic achievements!

Very nice talk by my PhD advisor Dr. Jean-Christophe Leroux from ETH Zurich at the CRS annual meeting Controlled Release Society #CRS2022! In his acceptance speech for the Samyang award, he talked about his research in hepatic encephalopathy and threw in some of my PhD work ETH Zurich


I curated an exclusive selection of highly impactful papers on the pharmacology of diabetes and its devastating complications: check this virtual issue (including editorial) out in ACS Pharmacology & Translational Science ACS Publications Bio & Med Chem Content! pubs.acs.org/page/aptsfn/vi…


Just published a perspective article in ACS Measurement Science ACS Analytical Chemistry Journals ACS Publications! With my grad student Tracy & undergrad Polina, we took a deep dive into the physics & (bio)chemistry of diagnostic bandages for diabetic wounds Matoori Lab Faculté de pharmacie PharmTech_UdeM

New paper out from my lab (clinical track): with PharmD students, we defined how community pharmacists can support intimate partner violence survivors Matoori Lab Faculté de pharmacie Great collab with Bharti Khurana, MD, MBA, FACR, FASER @EmaFer28 Dr Tamsin Higgs journals.sagepub.com/doi/10.1177/17…
